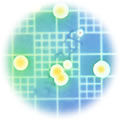

酵素なくして生命なし
酵素は、おそらく人間の体内に5,000種あるといわれていて、発見されているものだけでも2,500種あります。 酵素は、おそらく人間の体内に5,000種あるといわれていて、発見されているものだけでも2,500種あります。
その数多い酵素は、一体どんなはたらきをしているのでしょうか?
決して大げさな言い方をするわけではありませんが、「酵素なくして生命なし」と言ってもよい、たいへん重要なものなのです。
はたらきものの酵素
 例えば、私たちが毎日食べているごはんやパンですが、これらも酵素のはたらきなくしては決して栄養として私たちの体に吸収されることはありません。 例えば、私たちが毎日食べているごはんやパンですが、これらも酵素のはたらきなくしては決して栄養として私たちの体に吸収されることはありません。
ごはんやパンの主成分であるでんぷんは「グルコース」という糖がたくさん結合してできたたいへん大きな分子になっています。
口の中に入ったごはんやパンは、まず唾液中にある「αアミラーゼ」という酵素によって小さな糖に分解します。
ごはんをよく噛んでいると甘くなりますが、それは、このはたらきによるものなのです。
小腸でも酵素の仲間を含む消化液を分泌しています。
酵素の仲間のはたらきにより、口から入った食物の栄養素は、非常に小さな状態にまで分解され、初めて小腸の内壁にある「繊毛」と呼ばれる器官から吸収することができるのです。
しかし、食物の消化は、酵素がなす仕事のごく一部にすぎません。生きるために必要なエネルギーや体をつくる材料をつくっているのも酵素のはたらきによるものなのです。
髪が生えるのも酵素のおかげ?
 また髪が生えているのも、この酵素のはたらきによります。 また髪が生えているのも、この酵素のはたらきによります。
髪は血液中の赤血球とメラニンが酵素のはたらきで、日本人の場合ですと黒い髪となって生えてきます。
酵素は、体内で合成されるものですが、その酵素がはたらくためにはミネラルが欠かせません。
例えば、マグネシウムという1つのミネラルが不足しただけでも、325種の酵素がそのはたらきをストップします。
それほどミネラルは重要なものなのです。
ミネラル不足がヘアトラブルを・・・
しかし現代人の食生活は、非常にミネラルが不足してます。体内にミネラルが不足すると酵素もはたらきません。
つまり、正常な化学反応が行えず、白髪になったり、その他さまざまなヘアトラブルの原因になるわけです。
バン インターナショナルのヘアケア製品には、20種以上ものミネラルが含まれています。
食生活で不足しがちなミネラルを、頭皮からダイレクトに補給し、正常な化学反応を行わせることができます。
|